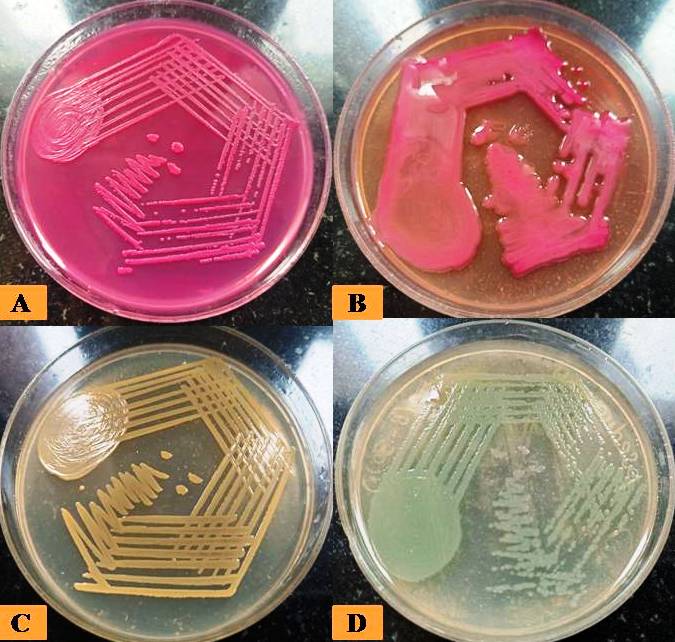
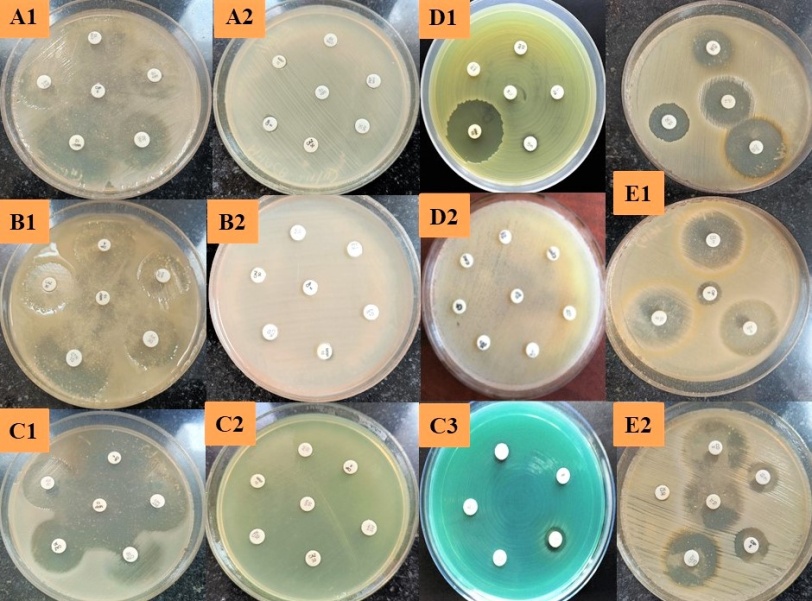

1,2Department of Microbiology, Shri Sathya Sai Medical College and Research Institute, Sri Balaji Vidyapeeth (Deemed to be University), Chengalpattu, Tamil Nadu 603108, 2Department of Microbiology, Shri Sathya Sai Medical College and Research Institute, Sri Balaji Vidyapeeth (Deemed to be University), Chengalpattu, Tamil Nadu 603108, 3Department of Microbiology, D. Y Patil Medical College Hospital and Research Center, DY Patil Vidyapeeth, Pimpri, Pune
Email: dr_prasanna85@yahoo.com
Received: 13 Dec 2022, Revised and Accepted: 09 Jan 2023
ABSTRAC
Objective: Wound infections lead to 70-80% mortality among post-surgeries and one-third of nosocomial infections. The prolonged hospitalization due to diagnostic tests, complete antibiotic course, and clearing of wound infection all together increase the healthcare cost.
Methods: The present study was a cross-sectional study carried out in the Department of Microbiology, Central laboratory, and teaching hospital from May 2022 to October 2022. All consecutive, non-duplicate gram-positive and gram-negative bacteria isolates were collected from pus and wound swabs from outpatients and hospitalized patients during the study period.
Results: A total of 260 isolates from various wound swabs and pus samples were collected from March 2022 to August 2022. Species-wise distribution of organisms along with antibiotic susceptibility testing shows that 15 out of 63 (24%) Escherichia coli, 12 out of 38 (31.5%) Klebsiella pneumoniae, 06 out of 29 (20.6%) P. aeruginosa, 06 out of 09 (40%) Acinetobacter baumannii, 05 out of 08 (62%) Klebsiella oxytoca, 04 out of 12 (33%) Citrobacter freundii, 01 out of 07 (14.3%) Enterobacter aerogenes were multi-drug-resistant (MDR). Previously few studies mentioned S. aureus was predominant, followed by P. aeruginosa in polymicrobial wound infections. Our study found that around 2-3% of cultures showed two organisms. The antibiotics like amikacin and imipenem worked well against all gram-negative organisms up to 72%, and 85%, respectively. Similar findings of organisms in other studies showed sensitivity to amikacin and imipenem up to 77% and 100%; 70% and 83%, respectively.
Conclusion: The organisms causing wound infections and the empirical therapy and switch to correct antibiotics as soon as possible to avoid misuse of antimicrobials and prevent the spread of drug-resistant strains among the community and hospital setup.
Keywords: Prevalence, Wound infection, Surgical site infection
© 2023 The Authors. Published by Innovare Academic Sciences Pvt Ltd. This is an open access article under the CC BY license (https://creativecommons.org/licenses/by/4.0/)
DOI: https://dx.doi.org/10.22159/ijpps.2023v15i3.47063. Journal homepage: https://innovareacademics.in/journals/index.php/ijpps.
The important organ in our body that defends the colonization of pathogens is skin. Therefore, the wound results from the breach in the normal anatomical structure and functions through surgeries or mechanical, disinfectants, antisepsis, and iatrogenic [1]. The wound healing and repair will be through regular phases in case of cuts, burns, abrasions, and surgical wounds. The wound healing rate and quality of life are compromised in the case of infected damage [2]. Wound infections lead to 70-80% mortality among post-surgeries and one-third of nosocomial diseases. The morbidity and mortality are more regardless of the type of wound because of Wound infections, especially in developing countries. The prolonged hospitalization due to diagnostic tests, complete antibiotic course, and clearing of wound infection all together increase the healthcare cost [2-5]. In association with diabetes or immunodeficiency diseases leads to delay in wound healing in chronic wounds like arterial and trophic ulcers [6].
Managing wound infections comprises two important aspects : wound care and antibiotic therapy [7]. The identification of microbial associated with wound infection, application of empirical antibiotics without sensitivity, and switch over to appropriate antibiotics after antibiotic sensitivity reports are helpful in the prevention of the spread of drug resistance, especially in hospitalized patients, which can reduce the healthcare cost [8, 9]. The organisms like Pseudomonas aeruginosa, Staphylococcus aureus, Klebsiella pneumoniae, Proteus species, Enterococcus faecalis, and Acinetobacter baumannii. During this first week, wound colonization is associated with Staphylococcus aureus followed by coagulase-negative Staphylococcus (CONS). Second-week wound colonization is associated with Pseudomonas and other gram-negative organisms [10, 11].
The ability to treat bacterial infections is critical in modern medicine. Without the help of antibiotics; many procedures in clinical settings would become unthinkable due to the risk of infections. Society has taken specific steps to restore antibiotic effectiveness like restrictions in use, antimicrobial stewardship and application of infection control guidelines. But unfortunately, the development of newer antibiotics and research and story for it has dwindled for various reasons [12, 13]. Control of hospital-acquired infections caused by multi-drug resistant Gram-negative bacilli is a significant problem. This led to therapeutic introduction of newer broad-spectrum antibiotics in hospitals, resulting in a subsequent increase in infections due to strictly aerobic Gram-negative bacilli, including Pseudomonas aeruginosa, Stenotrophomonas maltophilia and Acinetobacter species [13, 14].
Hospitals worldwide continue to face a crisis in the upsurge and dissemination of antimicrobial-resistant bacteria, mainly due to NFGNB causing nosocomial infections. The increasing prevalence of multidrug-resistant Pseudomonas aeruginosa and Acinetobacter baumannii organisms are alarming, as effective antibiotics are severely limited. There is evidence of a causal link between antibiotic consumption and resistance. Other factors such as inter-hospital transfer of patients, community contribution to resistance, structures of health care systems, infection control practices and policies may play a significant role in determining the prevalence of resistance in a hospital [15-17]. So the prevalence and phenotypic characterization of multi-drug-resistant isolates causing wound infections in a tertiary care centre guides society about its management.
Study design and sample processing
The present study was a cross-sectional study carried out in the Department of Microbiology, Central laboratory, and teaching hospital from May 2022 to October 2022 [IRC/2022/343]. All consecutive, non-duplicate gram-positive and gram-negative bacteria isolates were collected from pus and wound swabs from outpatients, and hospitalized patients were included during the study period. All other samples were excluded from this study. The phenotypic identification of various isolates was made taking into account the colony morphology, pigment production, and other biochemical tests. The sugar reactions, TSI, fermentation of sugars, indole, urea, citrate, motility, and glucose oxidative fermentative test (OF test), etc. [fig. 1, 2] were done for speciation of the Gram-positive and Gram-negative bacteria according to standard protocol.
Antimicrobial susceptibility
The antimicrobial susceptibility of all isolates was done by the Kirby-Bauer disk diffusion method according to the CLSI guidelines 2021. Susceptibility was done using Amikacin 30 μg, Amoxicillin/Clavulanic 20/10 μg, Ceftazidime 30 μg, Ciprofloxacin 5 μg, Colistin sulphate 10 μg, Cefotaxim 30 μg, Cefepime 30 μg, Nitrofurantoin 300 μg, Levofloxacin 5 μg, Sulphamethoxazole/ Trimethoprim 25 μg under standard conditions [fig. 3].
Statistical analysis
All the data in the present study was entered into a spreadsheet (Excel 2019; Microsoft) for analysis. The Unpaired student’s t-test was used as a test of significance for quantitative variables and a Chi-square test for qualitative variables. Yate’s correction was applied to the Chi-square test whenever the frequency of the variable was less than 5. All tests were two-tailed, and a p-value<0.05 was taken as significant.
All tests were done using online GraphPad software. http://www.graphpad.com/quickcalcs/contingency2/ and http://www.graphpad.com/quickcalcs/ttest2/.
Fig. 1-1A: Flat lactose fermenting colonies of Escherichia coli; 1B: Mucoid lactose fermenting colonies of Klebsiella pneumoniae; 1C: Golden yellow pigment producing colonies of Staphylococcus aureus; 1D: Bluish-green pigment producing colonies of Pseudomonas aeruginosa

Fig. 2: Biochemical reaction of organisms, 2A-positive tube coagulase by Staphylococcus aureus; 2B-mannitol fermenting Staphylococcus aureus; 2C-Indole positive, citrate not utilized, urea not hydrolyzed, acid/acid with gas production in tsi, motile in mannitol motility medium by Escherichia coli; 2D-Indole negative, citrate utilized, urea hydrolyzed, acid/acid with gas production in tsi, non-motile in mannitol motility medium by Klebsiella pneumoniae; 2E-Indole negative, citrate utilized, urea not hydrolyzed, alkaline/no change in tsi, motile in mannitol motility medium by Pseudomonas aeruginosa; 2F-Oxidase test positive (Pseudomonas aeruginosa) and negative (Acinetobacter baumannii)
Fig. 3: Antibiotic susceptibility testing-3A1: Sensitive Escherichia coli; 3A2: resistant Escherichia coli; 3B1: Sensitive Klebsiella pneumoniae; 3B2: Resistant Klebsiella pneumoniae; 3C1: Sensitive Pseudomonas aeruginosa; 3C2: Resistant pseudomonas aeruginosa; 3C3: Imipenem resistant Pseudomonas aeruginosa; 3D1: IMIPENEM SENSITIVE Acinetobacter baumannii; 3D2: Resistant Acinetobacter baumannii; 3E1: Sensitive Staphylococcus aureus; 3E2: Methicillin-resistant Staphylococcus aureus (MRSA) Showing resistance to cefoxitin
A total of 260 isolates from various wound swabs and pus samples were collected from March 2022 to August 2022. All isolates were screened for drug susceptibility by the Kirby-Bauer disk diffusion method, and the results were interpreted according to CLSI guidelines 2021. In this study, the Male: Female distribution of the sample was 172:88 (males: 66%; Females: 34%) [fig. 4]. For example, age distribution shows that most of the samples were from the age group 46-60 y followed by>60 y. [fig. 5, table 1]. Ward-wise distribution show that most of the samples in the present study were received from Surgery ICU 108 (41%) followed by Postoperative ward 72 (28%), surgery ward 53 (20%), and allied wards 27 (11%) [table 2, fig. 8]. Species-wise distribution of organisms causing wound infection shows that the most common isolate collected during the present study was Escherichia coli 63 (24%) followed by Staphylococcus aureus 49 (18.8%), Klebsiella pneumoniae 38 (15.1%), Pseudomonas aeruginosa 29 (11.3%), Acinetobacter baumannii 15 (5.78%), Citrobacter freundii 12 (4.5%), Klebsiella oxytoca 08 (3.04%), Enterobacter aerogenes 08 (3.04%), Enterococcus species 07 (2.6%), Proteus mirabilis 06 (2.3%), Streptococcus pyogenes 02 (0.78%), Proteus species 01 (0.39%), Streptococcus viridans 01 (0.39%) [table 3, fig. 7]. Species-wise distribution of organisms along with antibiotic susceptibility testing shows that 15 out of 63(24%) Escherichia coli, 12 out of 38 (31.5%) Klebsiella pneumoniae, 06 out of 29 (20.6%) P. aeruginosa, 06 out of 09 (40%) Acinetobacter baumannii, 05 out of 08 (62%) Klebsiella oxytoca, 04 out of 12 (33%) Citrobacter freundii, 01 out of 07 (14.3%) Enterobacter aerogenes were multi-drug-resistant (MDR) [table 4, fig. 8].

Fig. 4: Gender-wise distribution of wound infections
Table 1: Age-wise distribution of all samples (numbers and percentage)
| Age in years (range) | Number | Percentage |
| 0-15 | 10 | 4 |
| 16-30 | 23 | 8 |
| 31-45 | 53 | 21 |
| 46-60 | 112 | 43 |
| >60 | 62 | 24 |
| Total | 260 | 100 |

Fig. 5: Age-wise distribution of wound infections

Fig. 6: Ward-wise distribution of sample

Fig. 7: Species-wise distribution of organisms causing wound infections

Fig. 8: Species-wise distribution of multi-drug-resistant and nonmulti-drug-resistant organisms
Table 2: Ward-wise distribution of sample
| Ward | No. of samples | Percentage |
| Surgery ICU | 108 | 41 |
| Post-operative Ward | 72 | 28 |
| Surgery ward | 53 | 20 |
| Allied ward | 27 | 11 |
Table 3: Species-wise distribution in wound infection
| Organism | Total | Percentage |
| Escherichia coli | 63 | 24 |
| Staphylococcus aureus | 49 | 18.8 |
| Klebsiella pneumoniae | 38 | 15.1 |
| Pseudomonas aeruginosa | 29 | 11.3 |
| CONS | 21 | 8 |
| Acinetobacter species | 15 | 5.78 |
| Citrobacter freundii | 12 | 4.5 |
| Klebsiella oxytoca | 8 | 3.04 |
| Enterobacter aerogenes | 8 | 3.04 |
| Enterococcus species | 7 | 2.6 |
| Proteus mirabilis | 6 | 2.3 |
| Streptococcus pyogenes | 2 | 0.78 |
| Proteus species | 1 | 0.39 |
| Streptococcus viridans | 1 | 0.39 |
| Total | 260 |
| Organism | MDR | Percentage | Non-MDR | Percentage |
| Escherichia coli | 15 | 24 | 48 | 76 |
| Staphylococcus aureus | 0 | 0 | 49 | 100 |
| Klebsiella pneumoniae | 12 | 31.5 | 26 | 68.5 |
| Pseudomonas aeruginosa | 6 | 20.6 | 23 | 79.4 |
| CONS | 0 | 0 | 21 | 100 |
| Acinetobacter baumannii | 6 | 40 | 9 | 60 |
| Klebsiella oxytoca | 5 | 62 | 3 | 38 |
| Citrobacter freundii | 4 | 33 | 8 | 67 |
| Enterococci spp | 0 | 0 | 7 | 100 |
| Proteus mirabilis | 0 | 0 | 6 | 100 |
| Enterobacter aerogenes | 1 | 14.3 | 7 | 85.7 |
| Streptococcus pyogens | 0 | 0 | 2 | 100 |
| Proteus spp | 0 | 0 | 1 | 100 |
| Streptococcus spp | 0 | 0 | 1 | 100 |
| Total | 49 | 211 |
The detection and isolation of pathogenic organisms from various samples like wound swabs, pus or tissues by culture and sensitivity to guide the management of wound infections. Standardizing the diagnostic methods and improvising antibiotic stewardship will limit the spread of antibiotic resistance [1]. The present cross-sectional study, 14 microbial species were isolated from wound infections. The gram-negative bacteria were around 70%andthe Gram-positive bacteria were about 30%; similar results were also reported by Guan et al., Rahim K et al., and Wu YK et al. [18-20]. In this study, most of the wound infections were caused by single bacterial species, and a similar finding was reported by Mohammed et al. from wound swabs with 81.7% single bacterial growth [21]. WhereasGuan et al. and Yeong et al. showed multi-drug resistant polymicrobial cultures from wound infections within 72 h, and the predominant isolate was Staphylococcus aureus followed by Pseudomonas aeruginosa and Escherichia coli [18, 22]. Glik J et al. mentioned S. aureus was predominant, followed by P. aeruginosa in polymicrobial wound infections [23]. Our study found that 2-3% of cultures showed two organisms. However, the combination of two organisms has been reported with S. aureus in association with E. coli 6.8% and A. baumannii 5.1%. Similarly, polymicrobial infection by P. aeruginosais associated with P. mirabilis5.1%. The co-infection with three different organisms like K. pneumoniae, S. aureus, and S. marcescens has been observed in 3.4% of wound infections [18, 24-26]. The polymicrobial wound infections with these organisms make eradicating microorganisms more difficult. The Horizontal gene transfer between microorganisms enhances the non-healing tendency or chronic wound infections by polymicrobial organisms [24-29]. In the present study, we detected 18.8% of isolates showed multi-drug-resistance against at least five antimicrobial agents; in particular, the species involved were E. coli, K. pneumoniae, P. aeruginosa, A. baumannii, Citrobacter species and frequently seen isolate was methicillin-resistant Staphylococcus but not multi-drug-resistant. Co-infection is also seen among this organisms. The management of polymicrobial wound infections and its challenges are multi-drug resistance, biofilm formation, and tolerance to antimicrobials. The multi-target drugs or combination of a different group of drugs make them more bactericidal than giving higher antibiotics alone [28-32].
The multidrug-resistant E. coli, Klebsiella species, Citrobacter, Pseudomonas aeruginosa and Acinetobacter baumannii showed more resistance against ampicillin, followed by gentamicin, ceftriaxone, ceftazidime, piperacillin and ciprofloxacin [26-29, 33]. The antibiotics like amikacin, and imipenem worked well against all gram-negative multi-drug-resistant organisms in our study about 72%, and 85% respectively except a few isolates of Acinetobacter baumannii and Pseudomonas aeruginosa. Similarly organisms showed sensitivity to amikacin and imipenem by Guan et al. 77% and 100% and Li L et al.70% and 83%, respectively [18, 34]. Wong et al. reported chronic wound infections caused by gram-negative organisms showed a good response to amikacin and meropenem [26]. Our study showed vancomycin, and cotrimoxazole are more active against gram-positive organisms; several other studies supported the same [18, 26, 33-35]. Other studies carried out by Puca Vet al. [36] from 2017 to 2019 isolated more gram-negative organisms than gram-positive organisms; similar findings were reported in our research, including drug resistance.
The wound infections are further complicated in the presence of immunodeficiency, diabetes, and chronic vascular ulcers. Henceforth, understating the mechanism behind the wound and infections like pathogenic organisms are essential in the treatment and follow-up of patients. The microorganisms causing wound infections, increasing antimicrobial resistance towards them, and challenges in managing the same increase hospital stay and healthcare costs. This study highlights the prevalence of causative organisms and antimicrobial resistance in managing wound infections. This study will enlighten about organisms causing wound infections and the empirical therapy and switch over to correct antibiotics as soon as possible to avoid misuse of antimicrobials and to prevent the spread of drug-resistant strains among the community and hospital setup. Similar studies should in conducted in other hospital setups in a particular locality with antibiotic sensitivity, reasons for the spread of drug-resistant strains, and proper antibiotic stewardship can prevent the further spread of drug resistance.
Ms. Suganya, Ms. Chitra
The virulence factors and associated predisposition with wound infections and molecular level of characterization and drug-resistant genes detection of the different species were not able to be implemented. This study needs further extension work related proper selection of antibiotics and implementation of local antibiotic policy to prevent multi-drug resistance.
Nil
The Concept, the title, complete write-up, statistical analysis, photos, editing and presentation were done by Prasanna S (First and Corresponding author). The data collection, compilation of data, and pictures editing work were done by Anto PV (Second author). The Editing and compilation of details were done by Nikunja Kumar Das (Third author).
Nil
Maillard JY, Kampf G, Cooper R. Antimicrobial stewardship of antiseptics that are pertinent to wounds: the need for a united approach. JAC Antimicrob Resist. 2021;3(1):dlab027. doi: 10.1093/jacamr/dlab027, PMID 34223101.
Pallavali RR, Degati VL, Lomada D, Reddy MC, Durbaka VRP. Isolation and in vitro evaluation of bacteriophages against MDR-bacterial isolates from septic wound infections. PLOS ONE. 2017;12(7):e0179245. doi: 10.1371/journal.pone.0179245, PMID 28719657.
Anguzu JR, Olila D. Drug sensitivity patterns of bacterial isolates from septic post-operative wounds in a regional referral hospital in Uganda. Afr Health Sci. 2007;7(3):148-54. doi: 10.5555/afhs.2007.7.3.148, PMID 18052868.
Mehta RL, Kellum JA, Shah SV, Molitoris BA, Ronco C, Warnock DG. Acute kidney injury network: report of an initiative to improve outcomes in acute kidney injury. Crit Care. 2007;11(2):R31. doi: 10.1186/cc5713. PMID 17331245.
Agnihotri N, Gupta V, Joshi RM. Aerobic bacterial isolates from burn wound infections and their antibiograms–a five-year study. Burns. 2004;30(3):241-3. doi: 10.1016/j.burns.2003.11.010, PMID 15082351.
Taati MM, Khoshbayan A, Chegini Z, Farahani I, Shariati A. Bacteriophages, a new therapeutic solution for inhibiting multidrug-resistant bacteria causing wound infection: a lesson from animal models and clinical trials. Drug Des Dev Ther. 2020;14:1867.
Jeschke MG, Phelan HA, Wolf S, Romanowski K, Rehou S, Saetamal A. State of the science burn research: Burns in the elderly. J Burn Care Res. 2020;41(1):65-83. doi: 10.1093/jbcr/irz163, PMID 31999337.
Han G, Ceilley R. Chronic wound healing: a review of current management and treatments. Adv Ther. 2017;34(3):599-610. doi: 10.1007/s12325-017-0478-y, PMID 28108895.
Vaez H, Beigi F. Antibiotic susceptibility patterns of aerobic bacterial strains isolated from patients with burn wound infections. GERMS. 2016;6(1):34-6. doi: 10.11599/germs.2016.1087, PMID 27019830.
Glik J, Kawecki M, Gazdzik T, Nowak M. The impact of the types of microorganisms isolated from blood and wounds on the results of treatment in burn patients with sepsis. Pol Przegl Chir. 2012;84(1):6-16. doi: 10.2478/v10035-012-0002-7, PMID 22472489.
Huszczynski SM, Lam JS, Khursigara CM. The role of Pseudomonas aeruginosa lipopolysaccharide in bacterial pathogenesis and physiology. Pathogens. 2019;9(1):6. doi: 10.3390/pathogens9010006, PMID 31861540.
Spellberg B, Guidos R, Gilbert D, Bradley J, Boucher HW, Scheld WM. The epidemic of antibiotic-resistant infections: A call to action for the medical community from the Infectious Diseases Society of America. Clin Infect Dis. 2008;46(2):155-64. doi: 10.1086/524891, PMID 18171244.
Livermore DM. Current epidemiology and growing resistance of gram-negative pathogens. Korean J Intern Med. 2012;27(2):128-42.
Bergogne Berezin E, Towner KJ. Acinetobacter spp. As nosocomial pathogens: microbiological, clinical, and epidemiological features. Clin Microbiol Rev. 1996;9(2):148-65. doi: 10.1128/CMR.9.2.148, PMID 8964033.
Friedland I, Stinson L, Ikaiddi M, Harm S, Woods GL. Phenotypic antimicrobial resistance patterns in Pseudomonas aeruginosa and Acinetobacter: results of a multicenter intensive care unit surveillance study, 1995-2000. Diagn Microbiol Infect Dis. 2003;45(4):245-50. doi: 10.1016/s0732-8893(02)00503-5, PMID 12729994.
Falagas ME, Kasiakou SK, Nikita D, Morfou P, Georgoulias G, Rafailidis PI. Secular trends of antimicrobial resistance of blood isolates in a newly founded Greek hospital. BMC Infect Dis. 2006;6:99. doi: 10.1186/1471-2334-6-99, PMID 16776825.
Goel N, Wattal C, Oberoi JK, Raveendran R, Datta S, Prasad KJ. Trend analysis of antimicrobial consumption and development of resistance in non-fermenters in a tertiary care hospital in Delhi, India. J Antimicrob Chemother. 2011;66(7):1625-30. doi: 10.1093/jac/dkr167, PMID 21586594.
Guan H, Dong W, Lu Y, Jiang M, Zhang D, Aobuliaximu Y. Distribution and antibiotic resistance patterns of pathogenic bacteria in patients with chronic cutaneous wounds in China. Front Med (Lausanne). 2021;8:609584. doi: 10.3389/fmed.2021.609584, PMID 33816517.
Rahim K, Saleha S, Zhu X, Huo L, Basit A, Franco OL. Bacterial contribution in chronicity of wounds. Microb Ecol. 2017;73(3):710-21. doi: 10.1007/s00248-016-0867-9, PMID 27742997.
Wu YK, Cheng NC, Cheng CM. Biofilms in chronic wounds: pathogenesis and diagnosis. Trends Biotechnol. 2019;37(5):505-17. doi: 10.1016/j.tibtech.2018.10.011, PMID 30497871.
Mohammed A, Seid ME, Gebrecherkos T, Tiruneh M, Moges F. Bacterial isolates and their antimicrobial susceptibility patterns of wound infections among inpatients and outpatients attending the university of Gondar referral hospital, Northwest Ethiopia. Int J Microbiol. 2017;2017:8953829. doi: 10.1155/2017/8953829, PMID 28386280.
Yeong EK, Sheng WH, Hsueh PR, Hsieh SM, Huang HF, Ko AT. The wound microbiology and the outcomes of the systemic antibiotic prophylaxis in a mass burn casualty incident. J Burn Care Res. 2020;41(1):95-103. doi: 10.1093/jbcr/irz077, PMID 31999335.
Glik J, Kawecki M, Gazdzik T, Nowak M. The impact of the types of microorganisms isolated from blood and wounds on the results of treatment in burn patients with sepsis. Pol Przegl Chir. 2012;84(1):6-16. doi: 10.2478/v10035-012-0002-7, PMID 22472489.
Kathju S, Nistico L, Hall Stoodley L, Post JC, Ehrlich GD, Stoodley P. Chronic surgical site infection due to suture-associated polymicrobial biofilm. Surg Infect (Larchmt). 2009;10(5):457-61. doi: 10.1089/sur.2008.062, PMID 19811056.
Howell Jones RS, Wilson MJ, Hill KE, Howard AJ, Price PE, Thomas DW. A review of the microbiology, antibiotic usage and resistance in chronic skin wounds. J Antimicrob Chemother. 2005;55(2):143-9. doi: 10.1093/jac/dkh513, PMID 15649989.
Wong SY, Manikam R, Muniandy S. Prevalence and antibiotic susceptibility of bacteria from acute and chronic wounds in Malaysian subjects. J Infect Dev Ctries. 2015;9(9):936-44. doi: 10.3855/jidc.5882, PMID 26409734.
Serra R, Grande R, Butrico L, Rossi A, Settimio UF, Caroleo B. Chronic wound infections: Tthe role of Pseudomonas aeruginosa and staphylococcus aureus. Expert Rev Anti Infect Ther. 2015;13(5):605-13. doi: 10.1586/14787210.2015.1023291, PMID 25746414.
Usharani P. Incidence and outcome of multidrug-resistant aerobic gram-negative bacteria causing various clinical infections. Asian Journal of Pharmaceutical and Clinical Research. 2021 Dec 15;(2)2:123-6. doi: 10.22159/ajpcr.2022.v15i2.43436.
Mehta A, Diwakar MKR. Characterization and antimicrobial susceptibility profile of non-lactose fermenting gram-negative bacterial isolates in a tertiary care teaching hospital of central India. Asian Journal of Pharmaceutical and Clinical Research. 2021 Oct;14(10):41-7. doi: 10.22159/ajpcr.2021.v14i10.42822.
Agnihotri N, Gupta V, Joshi RM. Aerobic bacterial isolates from burn wound infections and their antibiograms-a five-year study. Burns. 2004;30(3):241-3. doi: 10.1016/j.burns.2003.11.010, PMID 15082351.
Grande R, Puca V, Muraro R. Antibiotic resistance and bacterial biofilm. Expert Opin Ther Pat. 2020;30(12):897-900. doi: 10.1080/13543776.2020.1830060, PMID 32985275.
Baffoni M, Bessa LJ, Grande R, Di Giulio M, Mongelli M, Ciarelli A. Laser irradiation effect on Staphylococcus aureus and Pseudomonas aeruginosa biofilms isolated from venous leg ulcer. Int Wound J. 2012;9:517–24.
Li L, Dai JX, Xu L, Chen ZH, Li XY, Liu M. Antimicrobial resistance and pathogen distribution in hospitalized burn patients: A multicenter study in Southeast China. Medicine. 2018;97(34):e11977. doi: 10.1097/MD.0000000000011977, PMID 30142829.
Vaez H, Beigi F. Antibiotic susceptibility patterns of aerobic bacterial strains isolated from patients with burn wound infections. Germs ERMS. 2016;6(1):34-36. doi: 10.11599/germs.2016.1087, PMID 27019830.
Kolar M, Cermak P, Hobzova L, Bogdanova K, Neradova K, Mlynarcik P. Antibiotic resistance in nosocomial bacteria isolated from infected wounds of hospitalized patients in czech republic. Antibiotics. 2020 Jun;9(6):342. doi: 10.3390/antibiotics9060342.
Puca V, Marulli RZ, Grande R, Vitale I, Niro A, Molinaro G. Microbial species isolated from infected wounds and antimicrobial resistance analysis: data emerging from a three-years retrospective study. Antibiotics (Basel). 2021;10(10):1162. doi: 10.3390/antibiotics10101162, PMID 34680743.